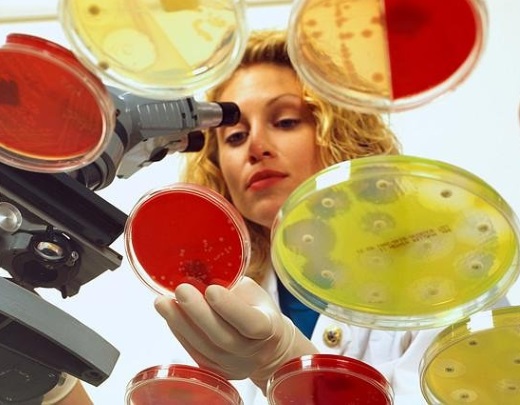

El consumo de antibióticos cae tres veces más en ganadería que en humana
24-04-2018
El consumo de dosis diarias de antibióticos en España ha descendido en los últimos dos años (2015 a 2017) un 5,42 % en lo que supone “una bajada significativa” y un cambio de la tendencia creciente que se registraba desde 2012. Por su parte, en ése mismo periodo se constató una bajada del 17 % en las ventas de antibióticos destinados a la salud animal. Así lo aseguró el secretario general de Sanidad, José Javier Castrodeza durante su comparecencia en la Comisión de Sanidad y Servicios Sociales del Congreso en la que informó sobre el Plan Nacional frente a la Resistencia de Antibióticos (PRAN) y de las reformas relativas a la política farmacéutico de su departamento.
El consumo de dosis diarias de antibióticos en España ha descendido en los últimos dos años (2015 a 2017) un 5,42 % en lo que supone “una bajada significativa” y un cambio de la tendencia creciente que se registraba desde 2012. Por su parte, en ése mismo periodo se constató una bajada del 17 % en las ventas de antibióticos destinados a la salud animal. Así lo aseguró el secretario general de Sanidad, José Javier Castrodeza durante su comparecencia en la Comisión de Sanidad y Servicios Sociales del Congreso en la que informó sobre el Plan Nacional frente a la Resistencia de Antibióticos (PRAN) y de las reformas relativas a la política farmacéutico de su departamento.
A pesar de estas reducciones, Castrodeza alertó de que alrededor de 25.000 personas fallecen en Europa como consecuencia de las bacterias multirresistentes, 2.837 de ellas en España, y se estima que dentro de 35 años el número de muertes anuales ascienda a 390.000, 40.000 en nuestro país.
“Debemos optimizar la prescripción en el ámbito de la sanidad humana, tanto en atención primaria como en hositales así como en sanidad animal”, destacó Castrodeza. El secretario de Sanidad también quiso aprovechar su comparecencia para lamentar que, desde 2008, sólo se hayan aprobado en la UE, 7 nuevos antibióticos al tiempo que advirtió que de los 51 que existen en desarrollo clínico a nivel mundial sólo 8 han sido catalogados como medicamentos ‘innovadores’.
A la cabeza
Estos datos oficiales se han dado a conocer coincidiendo con un segundo estudio internacional basado en las ventas de antibióticos en 76 países y referido a un periodo anterior, entre 2000 y 2015, al de los datos suministrados por el Ministerio de Sanidad. Efectivamente, según el referido informe publicado en la revista científica PNAS, el consumo total de antibióticos en España subió un 35% en ése tiempo, pasando de 500 millones a 700 millones de dosis diarias definidas (DDD). “La ratio per cápita subió un 17%, desde las 34,3 DDD a las 40,1 DDD por cada 1.000 habitantes y día. Es la ratio de uso más alta de cualquier país de ingresos altos y la tercera del global”, explicó el autor sénior del estudio y director del Centro para la Política, Economía y Dinámica de las Enfermedades (CDDEP), Ramanan Laxminarayan.
El que más entre los países ricos
España no aguanta la comparación con los países del norte de Europa. Entre los más ricos, los que menos abusan de los antibióticos son los noruegos, los suecos, los alemanes o los suizos. El caso más extremo puede ser el de los Países Bajos, donde hay un consumo per cápita de 15 DDD por las 40 de los españoles.

